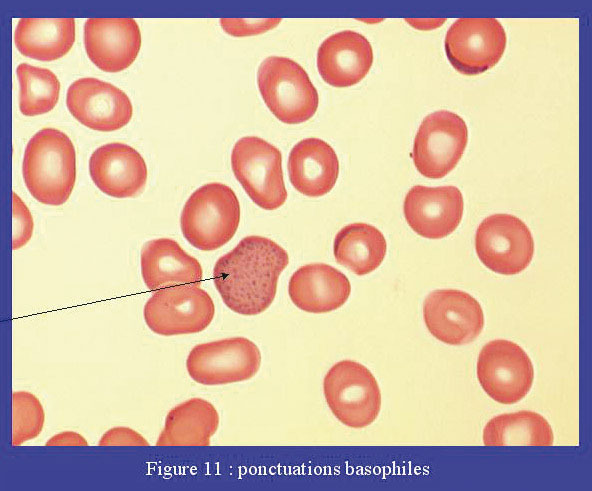

Les ponctuations basophiles sont les plus fréquentes. Elles sont formées d’agrégats de ribosomes et de polyribosomes. Ce sont de nombreuses granulations ressortant en bleu à la coloration de May-Grünwald-Giemsa, réparties uniformément dans l’ensemble du cytoplasme du globule rouge. On parle d’hématies ponctuées. Ces ponctuations basophiles se rencontrent dans les dysérythropoïèses congénitales ou acquises, les déficits en 5’pyrimidine-nucléotidase constitutionnels et acquis (intoxication au plomb), les anémies chroniques régénératives.